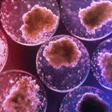
Idv, una legge per adottare

Una legge per adottare gli embrioni abbandonati. La proposta arriva dall'Italia dei Valori e mira a favorire l'adozione degli embrioni in sovrannumero ottenuti con la fecondazione artificiale e poi congelati, ai quali le coppie hanno rinunciato. Antonio Palagiano (Idv), vice presidente della Società italiana di Fertilità, Sterilità nel convegno sulla legge 40 e il turismo procreativo organizzato dalla stessa Idv e dalla Società spiega così la proposta: permettere l'adozione precoce dell'embrione, che, in altre parole, significa dare la possibilità a coppie di individui di sesso diverso, sposati o conviventi da almeno due anni, ma sterili, di rivolgersi al tribunale dei minori di riferimento per adottare un embrione abbandonato. In caso di adozione precoce, si prevede un solo tentativo per trasferire in utero un solo embrione. Tutto questo, naturalmente, rendendo anche "operativa la Biobanca per la crioconservazione degli embrioni abbandonati prevista presso l'ospedale Maggiore di Milano", dice Palagiano, "per la quale sono stati investiti 450mila euro e 74mila euro per il personale, sulla base rendiconto 2005". Sono 30mila, in Italia, gli embrioni prodotti in sovrannumero e congelati negli intyerventi di procreazione assistita prima della legge 40 (le norme in materia di procreazione medicalmente assistita vietano la creazione e la crioconservazione - congelamento - di embrioni in sovrannumero rispetto a quelli strettamente necessari ad un unico contemporaneo impianto, che comunque non possono essere più di tre); secondo il censimento dell'Istituto superiore di Sanità sono invece 2.527 quelli 'orfani', embrioni cioè i cui genitori biologici non sono stati rintracciati o che hanno dichiarato di volerli donare.